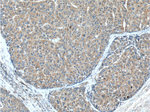
METTL9 Antibody in Immunohistochemistry (Paraffin) (IHC (P))

Search
Proteintech
METTL9 Polyclonal Antibody
{{$productOrderCtrl.translations['antibody.pdp.commerceCard.promotion.promotions']}}
{{$productOrderCtrl.translations['antibody.pdp.commerceCard.promotion.viewpromo']}}
{{$productOrderCtrl.translations['antibody.pdp.commerceCard.promotion.promocode']}}: {{promo.promoCode}} {{promo.promoTitle}} {{promo.promoDescription}}. {{$productOrderCtrl.translations['antibody.pdp.commerceCard.promotion.learnmore']}}
产品信息
15120-1-AP
种属反应
宿主/亚型
分类
类型
抗原
偶联物
形式
浓度
规格
纯化类型
保存液
内含物
保存条件
运输条件
产品详细信息
Immunogen sequence: MTSGPGGPA AAAGGRKENH QWYVCNREKL CESLQAVFVQ SYLDQGTQIF LNNSIEKSGW LFIQLYHSFV SSVFSLFMSR TSINGLLGRG SMFVFSPDQF QRLLKINPDW KTHRLLDLGA GDGEVTKIMS PHFEEIYATE LSETMIWQLQ KKKYRVLGIN EWQNTGFQYD VISCLNLLDR CDQPLTLLKD IRSVLEPTRG RVILALVLPF HPYVENVGGK WEKPSEILEI KGQNWEEQVN SLPEVFRKAG FVIEAFTRLP YLCEGDMYND YYVLDDAVFV LKPV (36-318 aa encoded by BC000195)
仅用于科研。不用于诊断过程。未经明确授权不得转售。
生物信息学
蛋白别名: CTB-31N19.3; DORA reverse strand protein; DORA reverse strand protein 1; DREV; hMETTL9; methyltransferase 9, His-X-His N1-histidine; methyltransferase like 9; Methyltransferase-like protein 9; mMETTL9; p53 activated protein 1; Protein-L-histidine N-pros-methyltransferase; unnamed protein product
基因别名: 0610012D09Rik; AA517660; CGI-81; DREV; DREV1; hMETTL9; METTL9; MNCb-5680; PAP1
UniProt ID: (Human) Q9H1A3, (Mouse) Q9EPL4
Entrez Gene ID: (Human) 51108, (Rat) 100302453, (Mouse) 59052